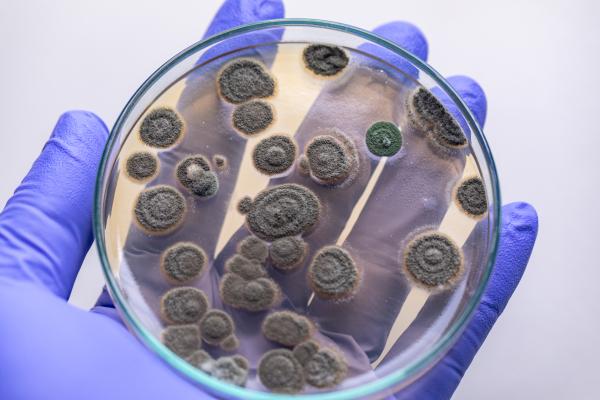
Biorremediación: qué es, tipos y ejemplos -  Ejemplos de biorremediación

Biorremediación: qué es, tipos y ejemplos


El acelerado desarrollo que ha tenido el ser humano desde la revolución industrial ha causado graves deterioros en el medio ambiente, que van desde la extracción intensiva de recursos naturales hasta la contaminación de ellos. En épocas recientes fue evidente la urgencia de tomar cartas sobre el asunto, y como resultado se han creado numerosas técnicas para devolver a los recursos naturales a su estado natural.
Como parte de la búsqueda por usar métodos menos invasivos, se desarrolló la biorremediación, que es sumamente novedosa dado que no utiliza químicos nocivos, sino que parte del principio de degradación y transformación propio de la naturaleza. Si quieres saber qué es la biorremediación, sus tipos y ejemplos, te invitamos a leer este artículo de BIOenciclopedia.
Qué es la biorremediación
La biorremediación es un método que utiliza diferentes seres vivos para recuperar recursos naturales que están contaminados, bajo el principio de que por naturaleza propia estos organismos pueden degradar ciertos compuestos. La meta de la biorremediación es dejar el ecosistema lo más parecido a como era originalmente, previo a los disturbios.
Las vías para eliminar los contaminantes son muchas. Pueden extraer completamente el contaminante, degradarlo a moléculas más sencillas, o transformarlas en otros componentes que no sean tan dañinos como los iniciales. Los organismos que pueden ser usados son hongos, plantas, algas, animales o bacterias. En la mayoría de los casos se tratan de microorganismos. La biorremediación puede estar dirigida a recuperar diferentes recursos, como son el suelo, el agua o el aire.
Tipos de biorremediación
La biorremediación puede clasificarse primero en el lugar donde se lleva a cabo. De este modo tenemos dos tipos:
- In situ: los organismos son usados directamente en el ecosistema que va a ser intervenido.
- Ex situ: aquí se excava el sitio para sacar el recurso y tratarlo en cámaras o biopilas fuera del lugar de origen.
También podemos clasificarla según las tecnologías de biorremediación, que son las que siguen:
- Fitorremediación: se utilizan diferentes tipos de plantas en suelos, agua o sedimentos para transformar los contaminantes, sea mediante la remoción, destrucción, transferencia o estabilización de estos.
- Biorreactores: son cápsulas cerradas donde hay mucho control, ideales para tratar residuos peligrosos. Dentro de ellos se puede combinar la biorremediación con procesos físicos y químicos para mejores resultados.
- Biolabranza: el suelo contaminado se combina con suelo sano y muchos nutrientes, removiéndolo constantemente para airearlo y que los microorganismos estén en óptimas condiciones para trabajar.
- Bioestimulación: a un recurso contaminado se agregan nutrientes para estimular el desarrollo de microbiota autóctona que degrade los contaminantes.
- Biodegradación en fase sólida: es una técnica ex situ en la que se toma un recurso contaminado, para llevarlo a compostaje o biopilas para que sean ahí remediados.
- Bioventeo: consiste en aplicar aire directamente a un suelo contaminado para que los contaminantes se biodegraden con ayuda de bacterias aerobias, es decir, que usan oxígeno, que son propias del suelo.
- Bioaumentación: a un recurso contaminado se adicionan directamente microorganismos para aumentar la posibilidad de degradar un contaminante en particular.
También te puede interesar leer este artículo sobre la Contaminación por basura: causas, consecuencias y soluciones.
Ejemplos de biorremediación
Existen varias estrategias que usan la biorremediación, y a continuación te presentamos algunos interesantes ejemplos para que comprendas mejor de qué se trata este concepto.
- Composteo de residuos peligrosos: el composteo convierte los residuos orgánicos en materia orgánica estable, y recientemente se ha descubierto que esta técnica puede ser utilizada para remediar suelos contaminados por sustancias peligrosas como pesticidas o solventes.
- Lirios acuáticos para limpiar cuerpos de agua: el lirio acuático tiene la capacidad de remover metales pesados del agua, como lo es por ejemplo el plomo.
- Microorganismos para degradar hidrocarburos: algunas bacterias y algas son capaces de usar a los hidrocarburos como fuente de energía para crecer, y se ha descubierto que todos los ecosistemas tienen algún microorganismo que los degrade, y mediante biorremediación es posible usarlos para recuperar suelos contaminados.
Importancia de la biorremediación
La biorremediación se ha convertido en una estrategia esencial en esta época industrializada, pues la producción y transformación produce una gran cantidad de desperdicios, muchos de ellos tóxicos, que son descargados en zonas naturales.
Los humanos dependemos directamente de estos recursos naturales, que nos proveen servicios ambientales como el transporte de agua y producción de oxígeno. Gracias a la biorremediación, existe la posibilidad de recuperar los ecosistemas que sustentan nuestra vida y la de millones de especies más. Al mismo modo, representa una alternativa a las técnicas que requieren grandes cantidades de químicos.
Aquí, te explicamos qué son los Recursos Naturales.
Ventajas y desventajas de la biorremediación
Entre las ventajas de la biorremediación están las siguientes:
- Los costos son muy bajos, a comparación de estrategias que requieren grandes inversiones en reactivos.
- No tiene efectos en la salud humana, como puede ocurrir en técnicas que usan químicos nocivos.
- Tampoco produce desechos que requieran tratamiento.
- Dado que los organismos son los que hacen todo el trabajo, es fácil de implementar.
Es importante considerar las desventajas que tiene esta práctica, entre las que se pueden enlistar:
- Limitación en la degradación de compuestos, dado que los organismos pueden no degradar por completo el contaminante.
- En algunos casos, la transformación puede producir compuestos más peligrosos que el que se buscaba eliminar inicialmente.
- Puede tomar más tiempo que otros métodos.
- La especificidad de los organismos debe ser muy alta para la degradación del contaminante deseado.
- Existen muchos factores que deben estar en ciertos parámetros para que los organismos remediadores funcionen. Estos factores pueden ser difíciles de regular y controlar.
Ahora que ya sabes qué es la biorremediación, sus tipos y ejemplos, te invitamos a leer este otro artículo sobre Qué es el impacto ambiental positivo y negativo.
Si deseas leer más artículos parecidos a Biorremediación: qué es, tipos y ejemplos, te recomendamos que entres en nuestra categoría de Contaminación.
- Velasco, J. A., & Sepúlveda, T. L. V. (2003). El composteo: una alternativa tecnológica para la biorremediación de suelos en México. Gaceta Ecológica, (66), 41-53.
- González, H. H. R., Bustillos, L. G. T., Fernández, I. M., Cortes, J. D. J. B., & Moroyoqui, P. G. (2010). Efectos de los surfactantes en la biorremediación de suelos contaminados con hidrocarburos. Química Viva, 9(3), 120-145.






